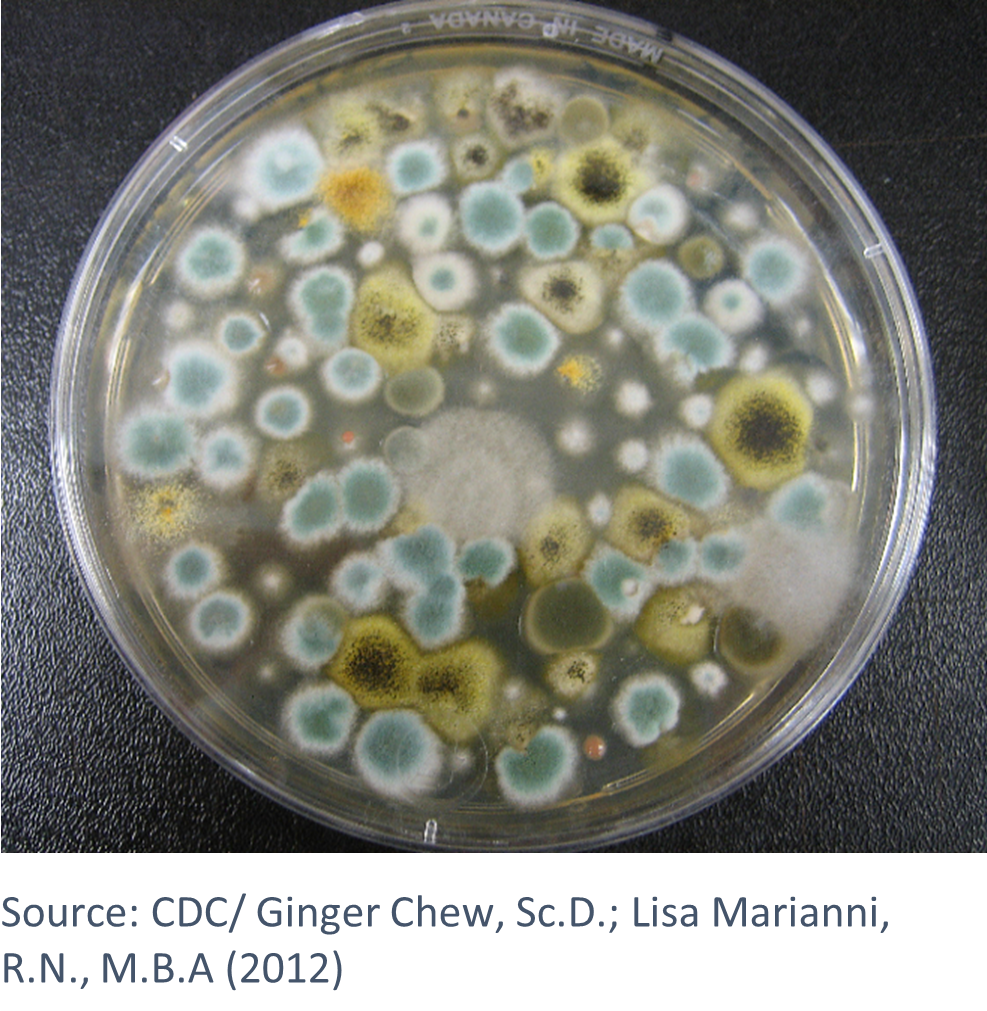
"Several mold-forming fungi"

Yeast, Mold, and Aerobic Actinomycete Testing at DSHS Laboratory
Source: CDC/ Dr. Lucille K. Georg (1955)
The DSHS Mycology Lab receives referred cultures of yeast, mold, and aerobic actinomycetes from other laboratories for identification. The referred specimens may be surveillance specimens or individual cases. This group of organisms are of public health concern because many of them are opportunistic pathogens that are difficult to treat with medication due to their multiple antimicrobial resistances.
Yeasts: Cryptococcus spp. and Candida spp.

Yeasts are a diverse group of single-celled organisms classified as fungi. Some yeasts, such as members of the genus Cryptococcus, and Candida are opportunistic pathogens that can cause disease in some people. Cryptococcus neoformans and C. gattii are species of yeast found in bird droppings, soil, on trees, and decaying vegetation that can cause disease in immunocompromised people if the microscopic yeast cells are inhaled.
Candida is a genus of yeast that is the leading cause of fungal illnesses in the world. Candida albicans normally lives on the skin and inside the body without causing illness but can cause oral and urogenital infections called candidiasis if it grows out of balance or gets into the bloodstream.
C. auris is a species that is a public health concern because of its multiple antimicrobial resistances, and it can be easily misidentified as other less dangerous Candida species. Healthy people usually do not get C. auris infections but C. auris can colonize the skin of healthy people, who can be asymptomatic carriers. People at the highest risk of developing a C. auris infection are usually patients who have been in a healthcare facility for a long time, who have invasive intubation in their body, or who have previously received antibiotics or antifungal medications.
For more information on Cryptococcus and Candida, please visit Candidiasis Basics | Candidiasis | CDC, Cryptococcosis | Cryptococcosis | CDC, and About Cryptococcosis | Cryptococcosis | CDC; Pneumocystis Pneumonia Basics | Pneumocystis Pneumonia | CDC; CDC - DPDx - Pneumocystis
Yeast Testing at the DSHS Austin Laboratory
The DSHS Laboratory carries out identification of yeast from clinical swabs and isolates, including Cryptococcus spp. and Candida auris. Colonization testing of individuals for C. auris is also available at the Lab. Please refer to the LTSM test menu for more details on the Lab’s yeast testing procedures and specimen submission requirements.
More information about C. auris identification and C. auris colonization testing at the Lab is available in the Texas AR Laboratory webpages.
Antimicrobial susceptibility testing on submitted yeast isolates is not available at DSHS Laboratory at this time. Isolates may be forwarded by DSHS to the Regional ARLN Laboratory for susceptibility testing.
Molds
A mold is a growth and reproductive structure certain fungi can form. A large and diverse group of fungi form molds. Several molds produce substances that inhibit the growth of bacteria, which are more commonly known as antibiotics. Aspergillus causes the most serious of mold illnesses. Aspergillus is a common environmental mold that can infect people with weakened immune systems or lung disease, causing a disease called aspergillosis. Aspergillosis can range from mild to serious.
Molds are commonly found in the environment, particularly in damp or humid conditions. Mold growth in homes and other buildings due to water leaks or flooding can pose a health hazard to humans by causing allergic reactions and respiratory issues such as asthma and pneumonia. Some mold species that grow on food items can produce toxic substances that can be ingested when contaminated food is eaten.
For more information on molds and fungal diseases, please visit Aspergillosis Basics | Aspergillosis | CDC.
Mold Testing at the DSHS Austin Laboratory
Identification of mold isolates, including Aspergillus, taken from human sources is available at the DSHS Laboratory. Pure isolates may be submitted on agar slants (Sabouraud Dextrose or Potato Dextrose). Isolates may also be submitted in liquid broth. Shipping plated medium supporting growth of molds is highly discouraged. Please refer to the LTSM test menu for more details on mold testing at the DSHS Laboratory.
NOTE: Drug susceptibility testing for molds is not available at the DSHS Lab. Isolates may be forwarded to a reference laboratory by DSHS at the submitter’s expense. Susceptibility testing at other reference labs is subject to those laboratories’ fees.
Aerobic Actinomycetes
The group of Gram-positive rod-like, filamentous organisms broadly known as "aerobic actinomycetes" is made up of several genera that grow and act as fungi but are true bacteria. Aerobic actinomycetes are found in many different environments and are not usually a part of the normal human microflora. Human infections by actinomycetes are normally opportunistic and caused by the microbes entering the body from the environment, usually via the lungs or by traumatic injury to the body. They cause several different diseases, most commonly in immunocompromised people.
Species of Nocardia cause a form of pneumonia that is most common in young, old, and people with chronic diseases or those who are immunocompromised. Aerobic actinomycete lung infections can spread to the brain. Nocardia skin infections can also occur and are usually caused by infected soil getting into open wounds. Nocardia brasiliensis, as well as Actinomadura madurae, and A. pelletieriare are common causes of mycetoma, a chronic skin infection characterized by nodules and lumps that is most frequently encountered in India, Sudan, Venezuela, and Mexico.
For more information on aerobic actinomycetes, please visit Nocardiosis | CDC.
Aerobic Actinomycetes Testing at the DSHS Austin Laboratory

The Lab accepts pure aerobic actinomycete isolates from human sources for morphological examination, High Performance Liquid Chromatography (HPLC) testing, and biochemical testing. Pure isolates may be submitted on solid or in liquid media.
Aerobic actinomycete cultures are subcultured to a panel of biochemical tests that require three weeks for results. All aerobic actinomycetes are analyzed by HPLC. The HPLC test indicates whether the tested organism produces mycolic acids, such as those produced by Nocardia species. The HPLC is not species specific but is often useful as an aid to determine the correct genus of the organism.
Identification of actinomycete isolates including Nocardia spp. and Actinomadura is also carried out at the Laboratory.
Please refer to the LTSM test menu for specimen submission and shipping requirements for aerobic actinomycete testing at the Laboratory.